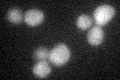
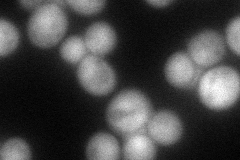
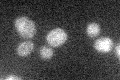

View description
Subunit VIb of cytochrome c oxidase, which is the terminal member of the mitochondrial inner membrane electron transport chain; required for assembly of cytochrome c oxidase but not required for activity after assembly; phosphorylated
Localization:
Intensity:
Fold change:
Significance:
-
C’ GFP library in SD
cytosol28.51 -
N' NOP1pr-GFP in SD

cytosol139.438 -
N' TEF2pr-mCherry in SD
cytosol60.7541 -
N' NATIVEpr-GFP in SD

missing0 -
N' TEF2pr-VC and Cyto-VN in SD

#N/A0 -
C’ GFP library in SD+DTT

cytosol26.380.92No -
C’ GFP library in SD+H2O2

cytosol29.871.04No -
C’ GFP library in Starvation Media
cytosol22.080.77No -
C’ GFP library on the background of Pup2-DaMP

cytosol -
C’ GFP library on the background of CCT mutant

cytosolN/AN/ANo
